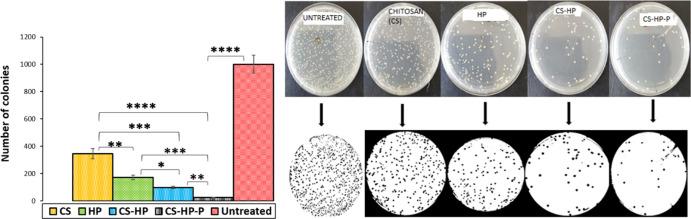
https://cdn.ncbi.nlm.nih.gov/pmc/blobs/9ecc/8412894/bb3209604b9d/ao1c02547_0011.jpg

用于双重递送抗微生物剂以对抗耐甲氧西林细菌生物膜感染伤口的壳聚糖基水凝胶
Chitosan-Based Hydrogel for the Dual Delivery of Antimicrobial Agents Against Bacterial Methicillin-Resistant Biofilm-Infected Wounds.
作者信息
Fasiku Victoria O, Omolo Calvin A, Devnarain Nikita, Ibrahim Usri H, Rambharose Sanjeev, Faya Mbuso, Mocktar Chunderika, Singh Sanil D, Govender Thirumala
机构信息
Discipline of Pharmaceutical Sciences, College of Health Sciences, University of KwaZulu-Natal, Private Bag X54001, Durban 4000, South Africa.
School of Pharmacy and Health Sciences, Department of Pharmaceutics, United States International University-Africa, P.O. Box 14634, Nairobi 00800, Kenya.
出版信息
ACS Omega. 2021 Aug 19;6(34):21994-22010. doi: 10.1021/acsomega.1c02547. eCollection 2021 Aug 31.
Chronic wound infections caused by antibiotic-resistant bacteria have become a global health concern. This is attributed to the biofilm-forming ability of bacteria on wound surfaces, thus enabling their persistent growth. In most cases, it leads to morbidity and in severe cases mortality. Current conventional approaches used in the treatment of biofilm wounds are proving to be ineffective due to limitations such as the inability to penetrate the biofilm matrix; hence, biofilm-related wounds remain a challenge. Therefore, there is a need for more efficient alternate therapeutic interventions. Hydrogen peroxide (HP) is a known antibacterial/antibiofilm agent; however, prolonged delivery has been challenging due to its short half-life. In this study, we developed a hydrogel for the codelivery of HP and antimicrobial peptides (Ps) against bacteria, biofilms, and wound infection associated with biofilms. The hydrogel was prepared via the Michael addition technique, and the physiochemical properties were characterized. The safety, , and antibacterial/antibiofilm activity of the hydrogel was also investigated. Results showed that the hydrogel is biosafe. A greater antibacterial effect was observed with HP-loaded hydrogels (CS-HP; hydrogel loaded with HP and CS-HP-P; hydrogel loaded with HP and peptide) when compared to HP as seen in an approximately twofold and threefold decrease in minimum inhibitory concentration values against methicillin-resistant (MRSA) bacteria, respectively. Similarly, both the HP-releasing hydrogels showed enhanced antibiofilm activity in the study in mice models as seen in greater wound closure and enhanced wound healing in histomorphological analysis. Interestingly, the results revealed a synergistic antibacterial/antibiofilm effect between HP and P in both and studies. The successfully prepared HP-releasing hydrogels showed the potential to combat bacterial biofilm-related infections and enhance wound healing in mice models. These results suggest that the HP-releasing hydrogels may be a superior platform for eliminating bacterial biofilms without using antibiotics in the treatment of chronic MRSA wound infections, thus improving the quality of human health.
由耐抗生素细菌引起的慢性伤口感染已成为全球卫生问题。这归因于细菌在伤口表面形成生物膜的能力,从而使其能够持续生长。在大多数情况下,会导致发病,严重时会导致死亡。由于存在无法穿透生物膜基质等局限性,目前用于治疗生物膜伤口的传统方法已被证明无效;因此,与生物膜相关的伤口仍然是一个挑战。所以,需要更有效的替代治疗干预措施。过氧化氢(HP)是一种已知的抗菌/抗生物膜剂;然而,由于其半衰期短,长时间递送一直具有挑战性。在本研究中,我们开发了一种用于共递送HP和抗菌肽(Ps)的水凝胶,以对抗细菌、生物膜以及与生物膜相关的伤口感染。通过迈克尔加成技术制备了水凝胶,并对其理化性质进行了表征。还研究了水凝胶的安全性、抗菌/抗生物膜活性。结果表明该水凝胶具有生物安全性。与HP相比,负载HP的水凝胶(CS - HP;负载HP的水凝胶和CS - HP - P;负载HP和肽的水凝胶)观察到了更强的抗菌效果,例如对耐甲氧西林金黄色葡萄球菌(MRSA)的最低抑菌浓度值分别降低了约两倍和三倍。同样,在小鼠模型研究中,两种释放HP的水凝胶均显示出增强的抗生物膜活性,如在组织形态学分析中伤口愈合更好且伤口愈合得到增强。有趣的是,结果显示在体外和体内研究中HP与P之间均存在协同抗菌/抗生物膜作用。成功制备的释放HP的水凝胶显示出在小鼠模型中对抗细菌生物膜相关感染并促进伤口愈合的潜力。这些结果表明,在治疗慢性MRSA伤口感染时,释放HP的水凝胶可能是一种无需使用抗生素即可消除细菌生物膜的优越平台,从而改善人类健康质量。